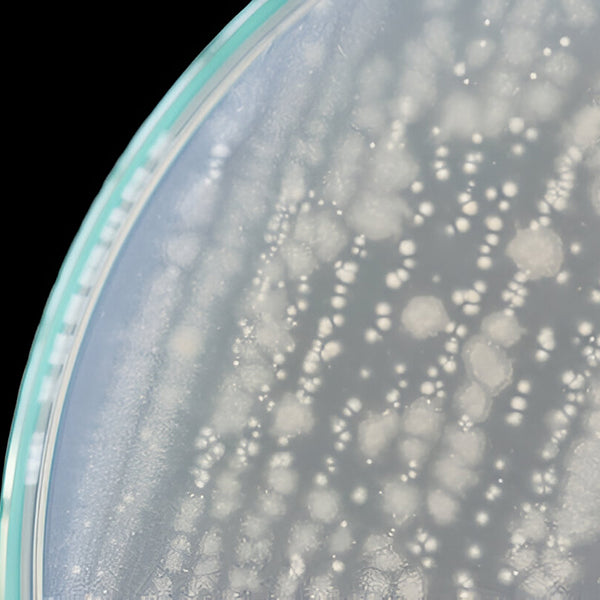

sh-Oligopeptide-1
Also known as Epidermal Growth Factor (EGF), supports skin regeneration, improving elasticity and firmness while reducing the appearance of fine lines.

Vegan Encapsulated Collagen
Vegan Encapsulated Collagen is a plant-based alternative designed to deliver hydration, support the skin's natural collagen production, and improve overall skin texture and elasticity.

Skin-mimetic Phospholipids
Bio-identical lipids mimic the skin’s natural phospholipids, strengthening the lipid barrier, enhancing hydration retention and delivering both short- and long-term hydration.

Tridecapeptide-1
A unique polypeptide helps reduce the appearance of fine lines, promoting a more even skin tone and texture.

S-mu-conotoxin cniiic
Helps to provide facial muscle relaxation, helping reduce the appearance of fine lines, and improve facial appearance.

Ceramide Complex
Provides hydration and comfort, while moisturizing and softening the skin.

Acetyl Tetrapeptide-2
A peptide known for its ability to improve skin elasticity and firmness. It works by supporting the production of collagen and elastin to promote a smoother, more toned complexion.

Marine Moisturizing Factor (MMF)
A seaweed-derived ingredient rich in amino acids, minerals and polysaccharides, it improves skin hydration by enhancing moisture retention, leaving the skin soft, smooth and supple.

Acetyl Hexapeptide-8
Helping relax tension in facial muscles, which helps reduce the appearance of fine lines, leading to a more youthful, refreshed appearance.

Kakadu Plum
This nutrient-rich fruit, known as the world's highest source of Vitamin C, that helps brighten the skin and improve overall skin tone evenness.

Hydrolyzed Rhodophyceae Extract
A red macroalgae that visibly regulates oily skin exposed to pollution.

Palmitoyl Tripeptide-5
It rejuvenates and smoothens the skin's appearance while improving firmness, elasticity, and overall texture for a more youthful look.

Caviar Lime
Offering skin exfoliation benefits, leaving the skin smoother, brighter, and more even toned.

Trifluoroacetyl Tripeptide-2
The biomimetic peptide supports collagen production, helping to maintain skin firmness and elasticity.

Acetyl Heptapeptide-4
Supports moisture retention by strengthening the skin’s barrier function and boosting its natural defense system by supporting a healthy skin microbiota, leaving the skin soft and smooth.

Glycosphingolipids & Glycolipids
This unique patented complex, naturally biomimetic and rich in linolenic acid, linoleic acid and oleic acid, deeply moisturizes and protects the skin. It refines skin texture, creating a smoother surface and a more uniform tone.

Agaric Acid
Acts as an astringent to tighten the skin, refine the appearance of pores, control excess sebum, and deliver a mattifying effect.

Palmitoyl Tripeptide-8
This soothing biomimetic lipopeptide, composed of three amino acids, helps calm redness, reduce irritation caused by UV and mechanical stress and strengthen the skin’s barrier.

Ectoin
An amino acid derivative that improves and energizes skin functions, supports the skin’s microbiome, and results in long-lasting and visible rejuvenation of youthful, healthy skin.

Zinc Hexapeptide Complex
A powerful retinol-like complex specifically designed to target excess sebum production, helping to balance oil levels in the skin.

Lingonberry Stem Cells Extract
Lingonberry stem cells, rich in bioactive molecules, stimulate the skin’s natural repair processes while improving hydration and preventing moisture loss.

Tripeptide-29
Support collagen production, helping to plump the skin and enhance firmness for a smoother, more youthful appearance.

Beta-Glucan
Rich in natural polysaccharides derived from mushrooms, it provides moisturization by attracting and locking in moisture to hydrate the skin.

Acetyl Tetrapeptide-5
A tetrapeptide that reduces puffy eyebags and dark circles, improves skin elasticity for a brighter eye contour.

Polylysine
A naturally derived lysine amino acid that balances the microbiome, reduces the appearance of blemishes and decreases sebum production to maintain a shine-free skin.

Vegan Biomimetic Marine Collagen
Vegan biomimetic marine collagen supports skin firmness and elasticity while improving hydration for a smoother complexion.

Nonapeptide-1
A biomimetic peptide that brightens the skin by regulating hyperpigmentation, providing better control over skin tone.

Hydroxypropyltrimonium Hyaluronate
Hydroxypropyltrimonium Hyaluronate carries a positive charge, and its modified structure helps create a barrier that locks in moisture, preventing water loss and ensuring long-lasting hydration.

Carrot Root Stem Cells
It provides skin hydration, a soothing effect and calms and protects the skin.

Pentapeptide-34
A bioengineered peptide that improves the skin’s natural antioxidant defense and energize the skin.

Ergothioneine
Ergothioneine is a sulfur-containing derivative of the amino acid histidine, is a uniquely stable antioxidant and cytoprotective agent that protects the skin from photoaging while improving roughness for a smoother skin texture.

Vegan Proteoglycan
Proteoglycan supports collagen density and enhances skin texture, promoting a smoother and more youthful appearance.

Prebiotics
Improves skin condition and combats photo-aging by regulating the interaction between skin microbiota and solar radiation, while boosting skin firmness.

γ-Aminobutyric Acid
GABA helps smooth the appearance of fine lines and expression lines while supporting skin hydration and elasticity for a smoother, youthful-looking complexion.

Acetyl Hexapeptide-1
A peptide known for its ability to reduce the appearance of fine lines by relaxing facial muscles, helping to smooth the skin.

Succinic Acid
Energizes tired skin, rejuvenating its appearance, helping increase radiance, and reducing signs of fatigue for a refreshed look.

Charcoal Beads
Provide mild exfoliation, helping to slough off dead skin cells and unclog pores.

α-Linolenic Acid
A highly effective ingredient that enhances skin tone uniformity by regulating hyperpigmentation and promoting a more balanced, radiant complexion.

Pomegranate Stem Cells
Improving skin brightness, evening skin tone and protecting against oxidative stress caused by sun exposure.

Heptapeptide-6
Improving moisture retention and strengthening the skin barrier, increasing antioxidant capacity and protection.

Amino Acids Blend (Alanine, Proline and Serine)
These amino acids help attract and retain moisture in the skin, keeping it hydrated and supple.

NMF mimicking blend
This blend of ingredients helps hydrate, smooth and support moisture retention, improving the overall texture of the skin.

Albatrellus Confluens
A unique mushroom it soothes and protects the skin while targeting factors that cause discomfort and irritation.

Oligopeptide-4
Evens skin tone and brings brightness to dull skin by helping reduce superficial melanin, enhancing and illuminating the complexion.

Pomegranate and Pumpkin Enzyme
Exfoliation is a key step in any skincare regimen, using Pomegranate Enzyme's proteolytic properties to gently remove the dead skin cells that trap bacteria and sebum.

Seaweeds
A unique source of highly bioactive molecules that promote skin tone uniformity while improving texture and firmness.

Oligopeptide-2
Helps restore skin vitality, detoxifies the eye contour area, smooths and reduces the appearance of dark circles for a refreshed and rejuvenated look.

Microalga Dunaliella Salina
Microalgae, a blend of active substances like amino acids and carbohydrates, helps brighten the skin by reducing dullness and promoting a luminous glow.

Red Marine Algae
Delivers short and long-term moisturization, promoting skin firmness, and soothes irritation for a healthier, more balanced complexion.

Cydonia Oblonga Leaf Extract
Cydonia Oblonga Leaf Extract helping to reduce shine and delivering a long-lasting mattifying effect.

Plankton Extract:
It helps protect against oxidative stress and provides long-lasting hydration while improving the appearance of fine lines.

Porphyridium Cruentum and Pullulan
A red microalgae known for its rich content of polysaccharides helps maintain hydration levels. Pullulan forms a thin film on the skin, providing a tightening effect, improving skin smoothness.

Arginine/lysine Polypeptides
It helps support elasticity, reduce skin roughness, and improve firmness for a smoother, more resilient appearance.

Peat Water Extract
Peat water contains a unique blend of bioactive compounds like fulvic and humic acids, which help to detoxify, hydrate and rejuvenate the skin naturally.
Bacillus Ferment
Provides effective protection against IR and UV rays, improving the skin barrier and helps maintain optimal hydration levels.

Fermented Golden Millet
Supports the skin's natural microbiota, boosts hydration and nourishes dry skin, promoting a healthy skin appearance.

Saccharomyces Cerevisiae
Rich in Oligo-β-glucans, it helps improve skin firmness, elasticity, and tonicity, promoting a more youthful and resilient appearance.

Unique Canadian Plant
It contains compounds such as flavonoids and tannins, which help calm irritation and reduce redness.

Yeast Extract
Rich in sulfur-containing peptides, it enhances complexion uniformity and amplifies depigmenting action for a brighter, even skin tone.

Acmella Oleracea Plant
Rich in spilanthol, a bioactive compound with muscle-relaxing properties, it helps minimizing the appearance of fine lines and promoting a smoother, more youthful appearance.

Baby Jackharides Extract
Gac fruit is packed with antioxidants, vitamins, and fatty acids which help to hydrate and lock in moisture, keeping the skin nourished and hydrated.

Dianthus Caryophyllus Flower Extract
Carnation flower extract helps support collagen production, improving skin's softness and promoting recovery and resilience for a smooth texture.

Trametes Versicolor
Native to the Himalayas, mushroom extract soothes and calms skin discomfort, helping to prevent irritation caused by factors like UV radiation.

Algae Water
Algal biological water hydrates, refreshes, and soothes the skin, promoting a smooth and revitalized look.

Cotton Seed Extract
Derived from plant stem cells, it supports the skin's natural defense mechanism to combat photodamage and prevent photo-aging.

Tetrapeptide-1
It helps support collagen production and improves skin elasticity. This peptide is also helping in reducing the appearance of fine lines and improving skin smoothness.

Echinacea Purpurea
Highly enriched in fatty acids, it offers a plumping and volumizing effect to the facial contour, supporting firmness and elasticity.

Lens Esculenta
Rich in oligosaccharides, lentil seed improves skin texture by reducing pore size and minimizing roughness, leaving the skin refined and smooth.

Spirodela Polyrhiza Extract
Spirodela Polyrhiza is a tiny aquatic plant renowned for its high nutritional and bioactive compound content, which hydrates the skin, helps maintain moisture levels, and leaves it soft and plump.

Sphingomonas Ferment Extract
A fermented microorganism derived from the rhizosphere of ginseng that improves skin hydration, enhances complexion radiance and improving overall skin quality.

Sunflower Sprout and Tara Tannins
Provides powerful protection against infrared and blue light while preventing the loss of skin density caused by sun exposure.

Bioactive Complex of 3 Tropical Fruits
Rich in vitamins, minerals, and enzymes, it helps nourish, moisturize and rejuvenate the skin.

Kale Leaf Extract
Kale, a sulfur-rich plant, gently exfoliates the skin, restores radiance, refines and softens skin texture resulting in a fine, smooth feel and a fresh, radiant complexion.

Cactus Extract
A natural form of Polyhydroxy acid that enhances the skin's natural exfoliation process and enhances radiance for a healthy, glowing complexion.

7 Swiss Mountain Plant Blend
A unique, naturally potent fusion of seven plants that improve skin brightness, improve skin tone, and keep it radiantly luminous.

Sea Vegetal Extract
Rejuvenates the eye contour, enhances skin firmness and reduces the appearance of dark circles for a more refreshed look.

Pepper Berry Extract
Minimizes the appearance of skin redness while soothing and relieving discomfort and itching

Artichoke Leaf Extract
Enhances skin elasticity while regulating hyperpigmentation and improving the appearance of noticeable pores

Haberlea Rhodopensis
Offers biomimetic control for skin rejuvenation, enhancing firmness and tone while delivering luminosity, and radiance.

Fagus Sylvatica Bud
Enhances skin hydration, smoothness and provides an energizing effect, leaving the skin visibly younger, smoother and hydrated.

Blend of 10 Chinese Herbs
A 10 renowned Chinese brightening herbs, it helps balance hyperpigmentation, provides hydration and improving the look of skin elasticity.

Alfalfa Extract + Lupine Protein
Packed with oligopeptides and oligosaccharides, it visibly diminishes eye bag volume while enhancing skin tone and restoring firmness for a refreshed, youthful look.

Elderberry Flower
Packed with flavonoids and polyphenols, this potent antioxidant helps diminish dark circles around the eyes, promoting a brighter, revitalized look.

Quinoa Seed Extract
Fades dark circles and reduces puffiness, revealing a radiant, refreshed and rejuvenated appearance.

Licorice Root Extract
Packed with glabridin, a powerful compound known for its ability to brighten and even out skin tone.

Shiitake Mushroom Ferment
Rich in natural compounds that minimize the appearance of dark spots and hyperpigmentation while brightening the overall skin tone.

Cherry Blossom
Inspired by Japanese beauty, it balances skin pigmentation and soothes irritation.

Centella Asiatica
Enhances skin radiance and tone, promoting a more uniform complexion for healthier, glowing skin.

Myrothamnus Flabellifolia
Rehydrates the skin, improves texture, protects against blue light stress, and reduces redness for a smoother, more balanced complexion.

Birch Sap Water
Its rich blend of amino acids, minerals, proteins, antioxidants and vitamins helps calm irritation, reduce redness and deliver hydration.

Myrrh Extract
Myrrh’s astringent properties help regulate sebum production while calming irritation and reducing redness.

White Willow Bark Extract
White willow bark extract helps reduce redness, alleviate irritation and gently exfoliate the skin for a smoother, calmer complexion.

Cornus Officinalis
Packed with fibers, vitamins, and organic acids, it works to calm irritated skin and visibly reduce redness.

Maclura Leaf Extract
Packed with bioflavonoids, it controls sebum levels, refines pore size and helps regulate the skin microbiome for a smoother, clearer complexion.